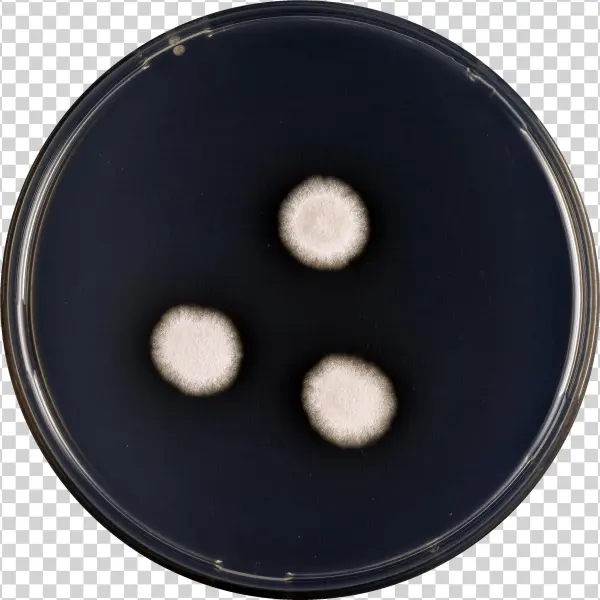
Aspergillus Subalbidus Cya

Aspergillus Subalbidus Cya

Accessories

Animals

Electronics

Festivals

Food

Nature

People

Social

Transportation

Vector
Aspergillus Subalbidus Cya
Description
Aspergillus Subalbidus Cya is a high-quality image available in full resolution.
Perfect for use in websites, blogs, presentations, and creative design projects.
This photo captures the essence of Aspergillus Subalbidus Cya with clarity and detail.
Suitable for personal and commercial use with no attribution required.
Explore more visuals related to
transparent, clipart, free png, icon, sticker.
PNG keywords
PNG info
Dimensions
2989x2989px
Filesize
4.98MB
MIME type
Image/png
Resize PNG
width(px)
height(px)
Non-commercial use, DMCA
Relevant png images